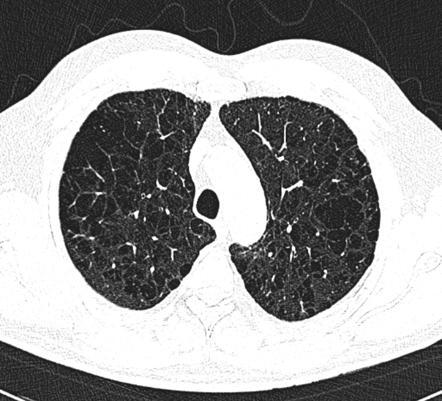

폐기종은 종말세기관지(terminal bronchiole) 원위부의 공기공간(air space)의 벽이 파괴되어 영구적으로 커진 것을 의미한다.
최근에는 폐기종을 임상적 용어로 사용하지는 않고 병리학적 용어로 사용한다.
임상적으로는 만성 기관지염, 기관지 천식, 기관지확장증과 함께 만성폐쇄성폐질환(COPD)으로 진단하고 치료를 한다.
다양한 종류의 폐기종이 있다. 범세엽(panacinar), 중심소엽(centrilobular), 격막주위(paraseptal) 및 반흔(cicatrical) 폐기종이 있다.
범세엽(panacinar) 폐기종은 종말세기관지 이하 모든 이차 폐소엽(secondary pulmonary lobule)이 침범된 경우다.
중심소엽(centrilobular) 폐기종은 주로 이차 폐소엽의 중심부위만을 침범한 경우다.
격막주의(paraseptal) 폐기종은 이차 폐소엽의 변연부만을 침번한 경우다.
반흔(cicatrical) 폐기종은 폐에 형성되어 있는 반흔 조직을 따라 불규칙하게 생기는 경우다.

1. X-ray
폐기종에 의해서 폐실질이 변화되어 방사선 투과성이 증가하여 정상인에 비해 흉부가 전체적으로 검게 보인다. 다만, X선 사진이 검은 것은 촬영조건에 따라 상당히 달라지기 때문에 주의를 요한다.

1-1. 폐의 과팽창
경한 폐기종에서는 찾기 힘들고 중등도나 심한 경우에 나타난다.
횡격막이 낮아지고 평편해진다. 측면 사진에서 흉곽의 전후경이 증가하여 술통(barrel chest) 같은 모양이 되고 흉골후방공간(retrosternal space)이 비정상적으로 넓어지고 길어지며 흉골이 전방으로 휜다.
1-2. 폐혈관의 변화
폐기종이 심해지면 말초 혈관의 수와 크기가 현저히 감소하고 중심혈관의 크기가 커진다. 폐동맥고혈압(pulmonary arterial hypertension)이 동반된다.
1-3. 심장의 변화
폐의 과팽창이 심해지면서 심장의 횡경이 작아지고 좀 더 중심부에 놓여진다. 폐성심(cor pulmonale)이 발생하면 우심실 확대소견이 나타난다.
1-4. 국소기포(bulla)나 소기포(bleb)
기포는 미만성 폐기종에 흔히 동반되며 주로 폐야의 변연부에 나타난다. 폐의 방사선 과투과로 X-ray로 찾기 어려울 수 있다.
2. CT
고해상 CT로 X-ray를 통해서 못 보는 경증의 폐기종, 작은 기포, 폐기종의 종류를 알 수 있다.
경계가 불분명한 저음영과 얇은 벽을 가진 기포, 폐혈관음영의 감소 등을 볼 수 있다.
'의학 공부' 카테고리의 다른 글
| 2형 당뇨병 약제 (0) | 2023.10.21 |
|---|---|
| 기관지협착(Bronchial stenosis) 영상소견 (0) | 2022.12.27 |
| 기관지확장증(Bronchiectasis) 영상소견 (0) | 2022.07.21 |
| 폐암 영상소견 (0) | 2022.07.20 |
| 폐결절 양성 vs 악성 영상소견 (0) | 2022.07.12 |